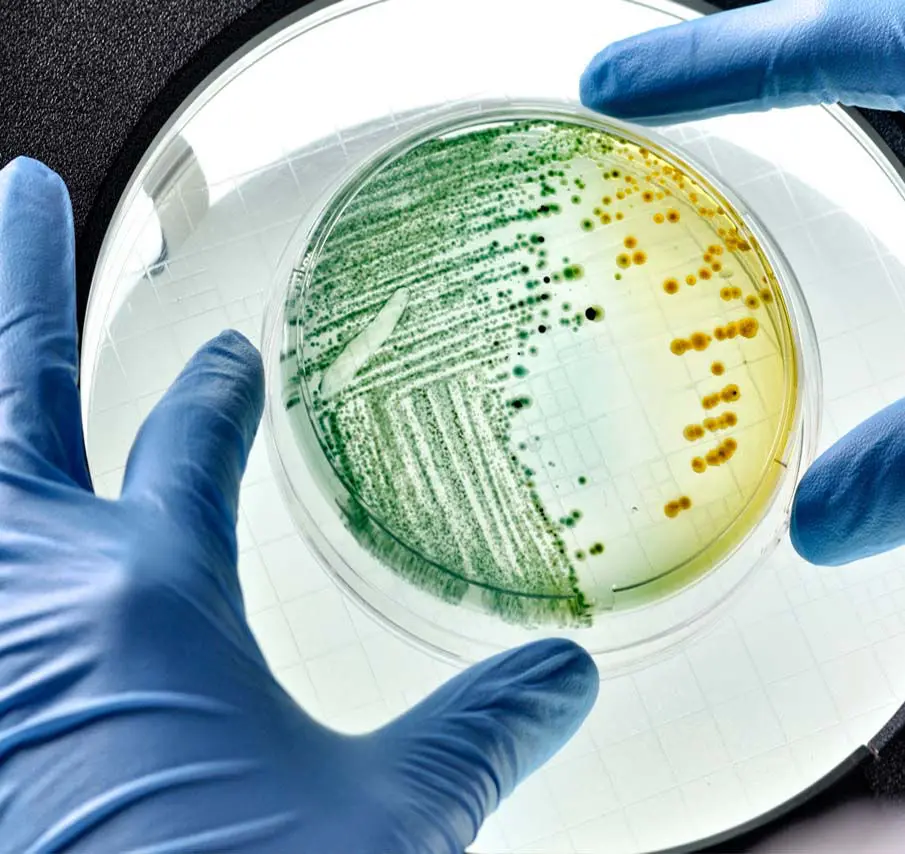

Yeshua Messiah

Reading assist
See where Yeshua is mentioned in the Old Testament / Tanakh -Torah
Understand Yeshua and what all He did in New Testament through the eyes of
Church of Antioch
Reach Yeshua through science that you were taught and believe in, yet you were not aware
Where is Yeshua is mentioned in Old Testament?
Prophecies fulfilled by Yeshua.
Isaac and Yeshuwa have a lot in common. Let us explore 30 odd similarities.
Let us explore the common events that happened in the life of Moses and Yeshuwa
Is He a Jew or a Catholic?
Is Yeshua a human or a God?
If He is God, how can He be servant?
How did the sacrifice of Yeshua replaced the Red heifer sacrifice to became
"The Ultimate Sacrifice"
There are many references about the bride of Yeshua. Who is this Bride?
A spiritual insight into the concept of
Trinity
Prayer and the meanings of
- Aboon d'Bashmayo
- Shlom lekh Mariam
We depend on eye witness and expert opinion as proof which is valid in Court of Law. Let us hear what they got to say.
Let us understand what the Black Hole Information Paradox and Bible has in common
See how The BIG BANG theory echoes what the Holy Bible have been telling us all along, yet went unnoticed


Tau תּ = Cross, Mark, Seal, Sign, Covenant…
Vav וֹ = Nail, Secure, Attach, Add, And…
Resh רָ = Head, Person, the Highest, Top, First, Firstborn…
He ה = Reveal, Behold, Look, Praise, The…



| Trinity | Verse from the Old Testament / Tanakh |
|---|---|
| Son | Psalms 2:7 I will declare the decree: the LORD hath said unto me, Thou art my Son; this day have I begotten thee. ( The Father declares this decree here ) |
| Son | Psalms 2:12 Kiss the Son, lest he be angry, and ye perish from the way, when his wrath is kindled but a little. Blessed are all they that put their trust in him. |
| Son | Psalms 110:1 The LORD said to my Lord, “Sit at My right hand, Till I make Your enemies Your footstool. |
| Son | Proverbs 30: 4 Who has ascended into heaven, or descended? Who has gathered the wind in His fists? Who has bound the waters in a garment? Who has established all the ends of the earth? What is His name, and what is His Son’s name, If you know? |
| Holy Spirit | Psalms 51:11 Do not cast me away from Your presence, And do not take Your Holy Spirit from me. |
| Holy Spirit | Isaiah 63: 10 But they rebelled and grieved His Holy Spirit; So He turned Himself against them as an enemy, And He fought against them. |
| Holy Spirit | Samson ( Judges 13:25, Judges 14:6, Judges 14:19, Judges 15:14), Daniel 4: 8, Daniel 4: 18-19. |
| Tanakh / Old Testament | New Testament |
|---|---|
| Isaiah 7:14 Therefore the Lord himself will give you a sign. Behold, the young unmarried woman shall conceive and bear a son, and shall call his name Immanuel. | Mathew 1:21 -23 She will give birth to a son, and you are to give him the name Yeshuwa, because he will save his people from their sins. All this took place to fulfill what the Lord had said through the prophet: “The virgin will conceive and give birth to a son, and they will call him Immanuel” (which means “God with us”). |
| Genesis 22:18 and in your offspring shall all the nations of the earth be blessed, because you have obeyed my voice. | Gal 3:16 Now the promises were spoken to Abraham and to his seed. He does not say, “And to seeds,” as referring to many, but rather to one, “And to your seed,” that is, Christ. |
| Hosea 11:1 When Israel was a child, I loved him, and out of Egypt I called my son. | Mathew 2: 14-15 When he arose, he took the young child and his mother by night, and departed into Egypt: And was there until the death of Herod: that it might be fulfilled which was spoken of the Lord by the prophet, saying, Out of Egypt have I called my son. |
| Isaiah 11:1 And there shall come forth a rod out of the stem of Jesse, and a Branch shall grow out of his roots: | Mathew 1: 1 The book of the generation of Jesus Christ, the son of David, the son of Abraham. |
| Genesis 49:10 The sceptre shall not depart from Judah, nor a lawgiver from between his feet, until Shiloh come; and unto him shall the gathering of the people be. | Luke 3:33 the son of Amminadab, the son of Ram, the son of Hezron, the son of Perez, the son of Judah |
| Micah 5:2 But thou, Bethlehem Ephratah, though thou be little among the thousands of Judah, yet out of thee shall he come forth unto me that is to be ruler in Israel; whose goings forth have been from of old, from everlasting. | Mathew 1: 3 Abraham begot Isaac, Isaac begot Jacob, and Jacob begot Judah and his brothers. Matthew 2:1-2 Now after Jesus was born in Bethlehem of Judea in the days of Herod the king, behold, wise men from the East came to Jerusalem, |
| Jeremiah 31:15 Thus says the LORD: "A voice is heard in Ramah, lamentation and bitter weeping. Rachel is weeping for her children; she refuses to be comforted for her children, because they are no more | Matthew 2:16-18 Then Herod, when he saw that he had been tricked by the wise men, became furious, and he sent and killed all the male children in Bethlehem and in all that region who were two years old or under, according to the time that he had ascertained from the wise men. Then was fulfilled what was spoken by the prophet Jeremiah: “A voice was heard in Ramah, weeping and loud lamentation, Rachel weeping for her children; she refused to be comforted, because they are no more.” |
| Isaiah 11:2 And the spirit of the LORD shall rest upon him, the spirit of wisdom and understanding, the spirit of counsel and might, the spirit of knowledge and of the fear of the LORD; | Luke 2:40 And the child grew, and waxed strong in spirit, filled with wisdom: and the grace of God was upon him. Luke 2:52 And Jesus increased in wisdom and stature, and in favour with God and man. |
| Isaiah 40:3-4 The voice of one crying in the wilderness: “Prepare the way of the LORD; Make straight in the desert A highway for our God. Every valley shall be exalted And every mountain and hill brought low; The crooked places shall be made straight And the rough places smooth; | John 1: 22 - 23 Then they said to him, “Who are you, that we may give an answer to those who sent us? What do you say about yourself?” He said: “I am ‘The voice of one crying in the wilderness: “Make straight the way of the LORD,” as the prophet Isaiah said.” Mark 1: 3 - 4 “The voice of one crying in the wilderness: ‘Prepare the way of the LORD; Make His paths straight.’ John came baptizing in the wilderness and preaching a baptism of repentance for the remission of sins. |
| 1 Samuel 2:35 ‘Then I will raise up for Myself a faithful priest who shall do according to what is in My heart and in My mind. I will build him a sure house, and he shall walk before My anointed forever. Note: The fulfillment of Priesthood getting stopped occurred when Solomon removed Abiathar the High Priest (1 Kings 2:26, 35) who was the last priest in the line of Eli. Thereafter, the descendants of Eleazar held the High Priesthood. | Hebrews 4:14-16 Seeing then that we have a great High Priest who has passed through the heavens, Jesus the Son of God, let us hold fast our confession. For we do not have a High Priest who cannot sympathize with our weaknesses, but was in all points tempted as we are, yet without sin. Let us therefore come boldly to the throne of grace, that we may obtain mercy and find grace to help in time of need. Note: Later, when Yeshua was born, Zachariah was a Priest from the Levite family line of Abijah. His son, John the Baptist was ordained by Holy Spirit, and John the Baptist gave the priesthood to Yeshua with Baptism since Yeshua insisted. Mathew 3 :14 - 15 But John tried to talk him out of it. “I am the one who needs to be baptized by you,” he said, “so why are you coming to me?” But Jesus said, “It should be done, for we must carry out all that God requires.” So John agreed to baptize him. |
| Psalms 110:4 The LORD hath sworn, and will not repent, Thou art a priest for ever after the order of Melchizedek. | Hebrew 5: 9- 10 And having been perfected, He became the author of eternal salvation to all who obey Him, called by God as High Priest “according to the order of Melchizedek,” |
| Isaiah 61:1-2 The Spirit of the Lord GOD is upon me; because the LORD hath anointed me to preach good tidings unto the meek; he hath sent me to bind up the brokenhearted, to proclaim liberty to the captives, and the opening of the prison to them that are bound; To proclaim the acceptable year of the LORD, and the day of vengeance of our God; to comfort all that mourn; | Luke 4: 18 - 21 Then He closed the book, and gave it back to the attendant and sat down. And the eyes of all who were in the synagogue were fixed on Him. And He began to say to them, “Today this Scripture is fulfilled in your hearing.” |
| Psalms 2: 7 I will declare the decree: The LORD has said to Me, ‘You are My Son, Today I have begotten You." | Mathew 3: 17 And suddenly a voice came from heaven, saying, “This is My beloved Son, in whom I am well pleased.” Mathew 17:5 While he was still speaking, behold, a bright cloud overshadowed them; and suddenly a voice came out of the cloud, saying, “This is My beloved Son, in whom I am well pleased. Hear Him!” |
| Isaiah 29:18-19 And in that day shall the deaf hear the words of the book, and the eyes of the blind shall see out of obscurity, and out of darkness. The meek also shall increase their joy in the LORD, and the poor among men shall rejoice in the Holy One of Israel. | Mathew 11: 3 - 5 and said to Him, “Are You the Coming One, or do we look for another?” Jesus answered and said to them, “Go and tell John the things which you hear and see: “The blind see and the lame walk; the lepers are cleansed and the deaf hear; the dead are raised up and the poor have the gospel preached to them. And blessed is he who is not offended because of Me." Luke 11:14 And He was casting out a demon, and it was mute. So it was, when the demon had gone out, that the mute spoke; and the multitudes marveled. |
| Isaiah 42: 1 - 4 "Behold! My Servant whom I uphold, My Elect One in whom My soul delights! I have put My Spirit upon Him; He will bring forth justice to the Gentiles. He will not cry out, nor raise His voice, Nor cause His voice to be heard in the street. A bruised reed He will not break, And smoking flax He will not quench; He will bring forth justice for truth. He will not fail nor be discouraged, Till He has established justice in the earth; And the coastlands shall wait for His law.” | Mathew 12: 15 - 21 But when Jesus knew it, He withdrew from there. And great multitudes followed Him, and He healed them all. Yet He warned them not to make Him known, that it might be fulfilled which was spoken by Isaiah the prophet, saying: “Behold! My Servant whom I have chosen, My Beloved in whom My soul is well pleased! I will put My Spirit upon Him, And He will declare justice to the Gentiles. He will not quarrel nor cry out, Nor will anyone hear His voice in the streets. A bruised reed He will not break, And smoking flax He will not quench, Till He sends forth justice to victory; And in His name Gentiles will trust. |
| Psalms 78:2 I will open my mouth in a parable; I will utter dark sayings of old, | Mathew 13: 34 All these things Jesus spoke to the multitude in parables; and without a parable He did not speak to them, |
| Psalms 69: 4 Those who hate me without a cause Are more than the hairs of my head; They are mighty who would destroy me, Being my enemies wrongfully; Though I have stolen nothing, I still must restore it. | John 15: 24 - 25 If I had not done among them the works which no one else did, they would have no sin; but now they have seen and also hated both Me and My Father. But this happened that the word might be fulfilled which is written in their law, ‘They hated Me without a cause.' |
| Zechariah 9: 9 Rejoice greatly, O daughter of Zion; shout, O daughter of Jerusalem: behold, thy King cometh unto thee: he is just, and having salvation; lowly, and riding upon an ass, and upon a colt the foal of an ass. | Mathew 21: 5 - 9 So the disciples went and did as Jesus commanded them. They brought the donkey and the colt, laid their clothes on them, and set Him on them. And a very great multitude spread their clothes on the road; others cut down branches from the trees and spread them on the road. Then the multitudes who went before and those who followed cried out, saying: “Hosanna to the Son of David! ‘Blessed is He who comes in the name of the LORD! Hosanna in the highest!” |
| Psalms 41: 9 Even my own familiar friend in whom I trusted, Who ate my bread, Has lifted up his heel against me. | John 13: 26 - 30 Jesus answered, “It is he to whom I shall give a piece of bread when I have dipped it.” And having dipped the bread, He gave it to Judas Iscariot, the son of Simon. Now after the piece of bread, Satan entered him. Then Jesus said to him, “What you do, do quickly.” .... ... Having received the piece of bread, he then went out immediately. And it was night. |
| Zechariah 11:12 - 13 Then I said to them, “If it is agreeable to you, give me my wages; and if not, refrain.” So they weighed out for my wages thirty pieces of silver. And the LORD said to me, “Throw it to the potter”—that princely price they set on me. So I took the thirty pieces of silver and threw them into the house of the LORD for the potter. | Mathew 27: 3 -10 Then Judas, His betrayer, seeing that He had been condemned, was remorseful and brought back the thirty pieces of silver to the chief priests and elders, saying, “I have sinned by betraying innocent blood.” And they said, “What is that to us? You see to it!” Then he threw down the pieces of silver in the temple and departed, and went and hanged himself.... ... And they consulted together and bought with them the potter’s field, to bury strangers in. ( It is also said that this land is also referred in Jeremaiah 32:7 - "Buy my field that is at Anathoth, for the right of redemption by purchase is yours." where God is referring Himself as the Potter earlier in the passage - Jeremaiah 18:1-6 ) |
| Zechariah 13: 7 Awake, O sword, against My Shepherd, Against the Man who is My Companion,” Says the LORD of hosts. “Strike the Shepherd, And the sheep will be scattered; Then I will turn My hand against the little ones. | Matthew 26:31 Then Jesus said to them, “All of you will be made to stumble because of Me this night, for it is written: ‘I will strike the Shepherd, And the sheep of the flock will be scattered |
| Exodus 12:5 ‘Your lamb shall be without blemish, a male of the first year. You may take it from the sheep or from the goats.' | 1 Peter 1:19 but with the precious blood of Christ, as of a lamb without blemish and without spot. |
| Isaiah 53: 7 He was oppressed and He was afflicted, Yet He opened not His mouth; He was led as a lamb to the slaughter, And as a sheep before its shearers is silent, So He opened not His mouth. | Mathew 27:12-14 And while He was being accused by the chief priests and elders, He answered nothing. Then Pilate said to Him, “Do You not hear how many things they testify against You?” But He answered him not one word, so that the governor marveled greatly. |
| Isaiah 63: 1 Who is this who comes from Edom, With dyed garments from Bozrah, This One who is glorious in His apparel, Traveling in the greatness of His strength?— “I who speak in righteousness, mighty to save. ”Why is Your apparel red, And Your garments like one who treads in the winepress? “ I have trodden the winepress alone, And from the peoples no one was with Me. For I have trodden them in My anger, And trampled them in My fury; Their blood is sprinkled upon My garments, And I have stained all My robes. For the day of vengeance is in My heart, And the year of My redeemed has come. I looked, but there was no one to help, And I wondered That there was no one to uphold; Therefore My own arm brought salvation for Me; And My own fury, it sustained Me. | Mathew 27: 28 - 29 And they stripped Him and put a scarlet robe on Him. When they had twisted a crown of thorns, they put it on His head, and a reed in His right hand. And they bowed the knee before Him and mocked Him, saying, “Hail, King of the Jews!” Revelation 19: 13 He was clothed with a robe dipped in blood, and His name is called The Word of God. |
| Isaiah 50: 6 I gave My back to those who struck Me, And My cheeks to those who plucked out the beard; I did not hide My face from shame and spitting. | Mathew 26: 67 Then they spat in His face and beat Him; and others struck Him with the palms of their hands, |
| Isaiah 53: 12 Therefore I will divide Him a portion with the great, And He shall divide the spoil with the strong, Because He poured out His soul unto death, And He was numbered with the transgressors, And He bore the sin of many, And made intercession for the transgressors. | Mathew 27: 38 Then two robbers were crucified with Him, one on the right and another on the left. |
| Isaiah 53: 5 But He was wounded for our transgressions, He was bruised for our iniquities; The chastisement for our peace was upon Him, And by His stripes we are healed. | Romans 5: 8 - 9 But God demonstrates His own love toward us, in that while we were still sinners, Christ died for us. Much more then, having now been justified by His blood, we shall be saved from wrath through Him. |
| Psalms 22: 1 My God, My God, why have You forsaken Me? Why are You so far from helping Me, And from the words of My groaning? | Mathew 27:46 And about the ninth hour Jesus cried out with a loud voice, saying, “Eli, Eli, lama sabachthani?” that is, “My God, My God, why have You forsaken Me?” |
| Psalms 69: 21 They also gave me gall for my food, And for my thirst they gave me vinegar to drink. | Mathew 27: 34 they gave Him sour wine mingled with gall to drink. But when He had tasted it, He would not drink. |
| Zechariah 12: 10 And I will pour on the house of David and on the inhabitants of Jerusalem the Spirit of grace and supplication; then they will look on Me whom they pierced. Yes, they will mourn for Him as one mourns for his only son, and grieve for Him as one grieves for a firstborn. Psalms 22:14 I am poured out like water, And all My bones are out of joint; My heart is like wax; It has melted within Me. | John 19:34 But one of the soldiers pierced His side with a spear, and immediately blood and water came out. |
| Psalms 34: 20 He guards all his bones; Not one of them is broken. | John 19: 33 But when they came to Jesus and saw that He was already dead, they did not break His legs. |
| Psalms 22: 18 They divide My garments among them, And for My clothing they cast lots. | John 19: 23 - 24 Then the soldiers, when they had crucified Jesus, took His garments and made four parts, to each soldier a part, and also the tunic. Now the tunic was without seam, woven from the top in one piece. They said therefore among themselves, “Let us not tear it, but cast lots for it, whose it shall be,” that the Scripture might be fulfilled which says: “They divided My garments among them, And for My clothing they cast lots.” Therefore the soldiers did these things. |
| Deuteronomy 21:23 his body shall not remain overnight on the tree, but you shall surely bury him that day, so that you do not defile the land which the LORD your God is giving you as an inheritance; for he who is hanged is accursed of God. | John 19:31 Therefore, because it was the Preparation Day, that the bodies should not remain on the cross on the Sabbath (for that Sabbath was a high day), ... Hebrew 13: 11 - 12 For the bodies of those animals, whose blood is brought into the sanctuary by the high priest for sin, are burned outside the camp. Therefore Jesus also, that He might sanctify the people with His own blood, suffered outside the gate. Galatians 3: 13 Christ has redeemed us from the curse of the law, having become a curse for us, for it is written, “Cursed is everyone who hangs on a tree" |
| Psalms 68:18 You have ascended on high, You have led captivity captive; You have received gifts among men, Even from the rebellious, That the LORD God might dwell there. | Acts 1: 9 - 10 Now when He had spoken these things, while they watched, He was taken up, and a cloud received Him out of their sight. And while they looked steadfastly toward heaven as He went up, behold, two men stood by them in white apparel, |
| Psalms 110:1 A Psalm of David. The LORD said to my Lord, “Sit at My right hand, Till I make Your enemies Your footstool.” | Mathew 22: 43-45 He said to them, “How then does David in the Spirit call Him ‘Lord,’ saying: The LORD said to my Lord, “Sit at My right hand, Till I make Your enemies Your footstool. If David then calls Him ‘Lord,’ how is He his Son? Acts 2: 33 - 36 Therefore being exalted to the right hand of God, and having received from the Father the promise of the Holy Spirit, He poured out this which you now see and hear. For David did not ascend into the heavens, but he says himself: ‘The LORD said to my Lord, “Sit at My right hand, Till I make Your enemies Your footstool. Therefore let all the house of Israel know assuredly that God has made this Jesus, whom you crucified, both Lord and Christ. Mark 14: 62 Jesus said, “I am. And you will see the Son of Man sitting at the right hand of the Power, and coming with the clouds of heaven.” Mark 16: 19 So then, after the Lord had spoken to them, He was received up into heaven, and sat down at the right hand of God. Hebrew 1 : 3- 6 who being the brightness of His glory and the express image of His person, and upholding all things by the word of His power, when He had by Himself purged our sins, sat down at the right hand of the Majesty on high, having become so much better than the angels, as He has by inheritance obtained a more excellent name than they. For to which of the angels did He ever say: “You are My Son, Today I have begotten You”? And again: “I will be to Him a Father, And He shall be to Me a Son”? But when He again brings the firstborn into the world, He says: "Let all the angels of God worship Him" 1 Corinthians 15: 25 - 28 For He must reign till He has put all enemies under His feet. The last enemy that will be destroyed is death. For “He has put all things under His feet.” But when He says “all things are put under Him,” it is evident that He who put all things under Him is excepted. Now when all things are made subject to Him, then the Son Himself will also be subject to Him who put all things under Him, that God may be all in all. |
| Sacrifice by | Verse from The Holy Bible |
|---|---|
| Cain | Genesis 4: 3 And in the process of time it came to pass that Cain brought an offering of the fruit of the ground to the LORD |
| Abel | Genesis 4: 4 Abel also brought of the firstborn of his flock and of their fat. And the LORD respected Abel and his offering, |
| Noah | Genesis 8: 20 - 21 Then Noah built an altar to the LORD, and took of every clean animal and of every clean bird, and offered burnt offerings on the altar. And the LORD smelled a soothing aroma. Then the LORD said in His heart, “I will never again curse the ground for man’s sake, although the imagination of man’s heart is evil from his youth; nor will I again destroy every living thing as I have done. |
| Abraham | Genesis 22: 2 Then He said, “Take now your son, your only son Isaac, whom you love, and go to the land of Moriah, and offer him there as a burnt offering on one of the mountains of which I shall tell you.” Genesis 22: 8 - 9 And Abraham said, “My son, God will provide for Himself the lamb for a burnt offering.” So the two of them went together. Then they came to the place of which God had told him. And Abraham built an altar there and placed the wood in order; and he bound Isaac his son and laid him on the altar, upon the wood. |
| Isaac | Genesis 27: 3 - 4 “Now therefore, please take your weapons, your quiver and your bow, and go out to the field and hunt game for me. And make me savory food, such as I love, and bring it to me that I may eat, that my soul may bless you before I die.” |
| Jacob | Genesis 31: 54 Then Jacob offered a sacrifice on the mountain, and called his brethren to eat bread. And they ate bread and stayed all night on the mountain. Genesis 46: 1 So Israel took his journey with all that he had, and came to Beersheba, and offered sacrifices to the God of his father Isaac. |
| Moses | Leviticus 9: 2 And he said to Aaron, “Take for yourself a young bull as a sin offering and a ram as a burnt offering, without blemish, and offer them before the LORD. |
| David | 2 Samuel 24: 25
And David built there an altar to the LORD, and offered burnt offerings and peace offerings. So the LORD heeded the prayers for the land, and the plague was withdrawn from Israel. |
| Solomon | 1 Kings 8: 63 And Solomon offered a sacrifice of peace offerings, which he offered to the LORD, 22,000 bulls and 1,20,000 sheep. So the king and all the children of Israel dedicated the house of the LORD. |
| For all Israel | Leviticus 1: 3 - 17 ‘If his offering is a burnt sacrifice of the herd, let him offer a male without blemish; he shall offer it of his own free will at the door of the tabernacle of meeting before the LORD. ..... It is a burnt sacrifice, an offering made by fire, a sweet aroma to the LORD. |
| Hebrew 9: 2 - 5 |
|---|
| For a tabernacle was prepared: the first part, in which was the lampstand, the table, and the showbread, which is called the sanctuary; and behind the second veil, the part of the tabernacle which is called the Holiest of All, which had the golden censer and the ark of the covenant overlaid on all sides with gold, in which were the golden pot that had the manna, Aaron’s rod that budded, and the tablets of the covenant; and above it were the cherubim of glory overshadowing the mercy seat. Of these things we cannot now speak in detail. |
| Hebrew 9: 6 - 7 |
|---|
| Now when these things had been thus prepared, the priests always went into the first part of the tabernacle, performing the services. But into the second part the high priest went alone once a year, not without blood, which he offered for himself and for the people’s sins committed in ignorance; |

But the goat on which the lot fell to be the scapegoat shall be presented alive before the LORD, to make atonement upon it, and to let it go as the scapegoat into the wilderness.
And Aaron shall bring the bull of the sin offering, which is for himself, and make atonement for himself and for his house, and shall kill the bull as the sin offering which is for himself.
Then he shall take a censer full of burning coals of fire from the altar before the LORD, with his hands full of sweet incense beaten fine, and bring it inside the veil.
And he shall put the incense on the fire before the LORD, that the cloud of incense may cover the mercy seat that is on the Testimony, lest he die.
He shall take some of the blood of the bull and sprinkle it with his finger on the mercy seat on the east side; and before the mercy seat he shall sprinkle some of the blood with his finger seven times.
Then he shall kill the goat of the sin offering, which is for the people, bring its blood inside the veil, do with that blood as he did with the blood of the bull, and sprinkle it on the mercy seat and before the mercy seat.
So he shall make atonement for the Holy Place, because of the uncleanness of the children of Israel, and because of their transgressions, for all their sins; and so he shall do for the tabernacle of meeting which remains among them in the midst of their uncleanness.
There shall be no man in the tabernacle of meeting when he goes in to make atonement in the Holy Place, until he comes out, that he may make atonement for himself, for his household, and for all the assembly of Israel.
And he shall go out to the altar that is before the LORD, and make atonement for it, and shall take some of the blood of the bull and some of the blood of the goat, and put it on the horns of the altar all around.
Then he shall sprinkle some of the blood on it with his finger seven times, cleanse it, and consecrate it from the uncleanness of the children of Israel.
| Verse from The Old Testament / Tanakh |
|---|
| 1 Kings 11 : 4 For it was so, when Solomon was old, that his wives turned his heart after other gods; and his heart was not loyal to the LORD his God, as was the heart of his father David. |
| 2 Kings 7: 10 - 14 They set up for themselves sacred pillars and wooden images on every high hill and under every green tree. There they burned incense on all the high places, like the nations whom the LORD had carried away before them; and they did wicked things to provoke the LORD to anger, for they served idols, of which the LORD had said to them, “You shall not do this thing.” Yet the LORD testified against Israel and against Judah, by all of His prophets, every seer, saying, “Turn from your evil ways, and keep My commandments and My statutes, according to all the law which I commanded your fathers, and which I sent to you by My servants the prophets.” Nevertheless they would not hear, but stiffened their necks, like the necks of their fathers, who did not believe in the LORD their God. |
| 2 Kings 17: 18 - 23 Therefore the LORD was very angry with Israel, and removed them from His sight; there was none left but the tribe of Judah alone. Also Judah did not keep the commandments of the LORD their God, but walked in the statutes of Israel which they made. And the LORD rejected all the descendants of Israel, afflicted them, and delivered them into the hand of plunderers, until He had cast them from His sight. For He tore Israel from the house of David, and they made Jeroboam the son of Nebat king. Then Jeroboam drove Israel from following the LORD, and made them commit a great sin. For the children of Israel walked in all the sins of Jeroboam which he did; they did not depart from them, until the LORD removed Israel out of His sight, as He had said by all His servants the prophets. So Israel was carried away from their own land to Assyria, as it is to this day. |
| 2 Kings 17: 38 - 41 “And the covenant that I have made with you, you shall not forget, nor shall you fear other gods. But the LORD your God you shall fear; and He will deliver you from the hand of all your enemies.” However they did not obey, but they followed their former rituals. So these nations feared the LORD, yet served their carved images; also their children and their children’s children have continued doing as their fathers did, even to this day. |
| Jeremiah 7: 28 “So you shall say to them, ‘This is a nation that does not obey the voice of the LORD their God nor receive correction. Truth has perished and has been cut off from their mouth.' |
| Verse from The Holy Bible |
|---|
| Jeremiah 31: 31 - 32 Behold, the days are coming, says the LORD, when I will make a new covenant with the house of Israel and with the house of Judah. "not according to the covenant that I made with their fathers in the day that I took them by the hand to lead them out of the land of Egypt, My covenant which they broke, though I was a husband to them," says the LORD |
| Jeremiah 31: 33 - 34 But this is the covenant that I will make with the house of Israel after those days, says the LORD: I will put My law in their minds, and write it on their hearts; and I will be their God, and they shall be My people. No more shall every man teach his neighbor, and every man his brother, saying, ‘Know the LORD,’ for they all shall know Me, from the least of them to the greatest of them, says the LORD. For I will forgive their iniquity, and their sin I will remember no more. |
| Hebrew 8: 7 - 13 In that He says, “A new covenant,” He has made the first obsolete. Now what is becoming obsolete and growing old is ready to vanish away. |
| Verse from The Holy Bible |
|---|
| Hebrew 7: 1 - 28 For this Melchizedek, king of Salem, priest of the Most High God, who met Abraham returning from the slaughter of the kings and blessed him, to whom also Abraham gave a tenth part of all, first being translated “king of righteousness,” and then also king of Salem, meaning “king of peace,” without father, without mother, without genealogy, having neither beginning of days nor end of life, but made like the Son of God, remains a priest continually. Now consider how great this man was, to whom even the patriarch Abraham gave a tenth of the spoils And indeed those who are of the sons of Levi, who receive the priesthood, have a commandment to receive tithes from the people according to the law, that is, from their brethren, though they have come from the loins of Abraham; but he whose genealogy is not derived from them received tithes from Abraham and blessed him who had the promises. Now beyond all contradiction the lesser is blessed by the better. Here mortal men receive tithes, but there he receives them, of whom it is witnessed that he lives. Even Levi, who receives tithes, paid tithes through Abraham, so to speak, for he was still in the loins of his father when Melchizedek met him. Therefore, if perfection were through the Levitical priesthood (for under it the people received the law), what further need was there that another priest should rise according to the order of Melchizedek, and not be called according to the order of Aaron? For the priesthood being changed, of necessity there is also a change of the law. For He of whom these things are spoken belongs to another tribe, from which no man has officiated at the altar. For it is evident that our Lord arose from Judah, of which tribe Moses spoke nothing concerning priesthood. And it is yet far more evident if, in the likeness of Melchizedek, there arises another priest who has come, not according to the law of a fleshly commandment, but according to the power of an endless life. For He testifies: “You are a priest forever According to the order of Melchizedek." For on the one hand there is an annulling of the former commandment because of its weakness and unprofitableness, for the law made nothing perfect; on the other hand, there is the bringing in of a better hope, through which we draw near to God. And in as much as He was not made priest without an oath (for they have become priests without an oath, but He with an oath by Him who said to Him: “The LORD has sworn And will not relent, ‘You are a priest forever According to the order of Melchizedek’ ”) by so much more Jesus has become a surety of a better covenant. Also there were many priests, because they were prevented by death from continuing. But He, because He continues forever, has an unchangeable priesthood. |

Order of Melchizedek with Bread and Wine

Yeshua continuing the order of Melchizedek with Bread and Wine


"Therefore it was necessary that the copies of the things in the heavens should be purified with these, but the heavenly things themselves with better sacrifices than these.
For Christ has not entered the holy places made with hands, which are copies of the true, but into heaven itself, now to appear in the presence of God for us;
not that He should offer Himself often, as the high priest enters the Most Holy Place every year with blood of another— He then would have had to suffer often since the foundation of the world; but now, once at the end of the ages,
He has appeared to put away sin by the sacrifice of Himself. And as it is appointed for men to die once, but after this the judgment, so Christ was offered once to bear the sins of many. To those who eagerly wait for Him He will appear a second time, apart from sin, for salvation. "
- Hebrew 9: 23 - 28
For the bodies of those animals, whose blood is brought into the sanctuary by the high priest for sin, are burned outside the camp.
Therefore Jesus also, that He might sanctify the people with His own blood, suffered outside the gate.
Therefore let us go forth to Him, outside the camp, bearing His reproach.
For here we have no continuing city, but we seek the one to come.
- Hebrew 13: 11 - 14

Location of Chromosome in a human cell
- Magnified image of an average Human Chromosome.
- Average Human cell will have 23 pairs, totalling 46 Chromosomes (23 x 2)
- One pair determines the gender of that human, as XY or XX.

An normal human chromosome as seen under a microscope by human eyes. A total of 46 chromosomes can be seen.

Ron and Isreali lab technicians saw the chromosome under a microscope, that was still alive even after 2000 years, with only 24 chromosomes. They said it was impossible for such a blood to be alive.

As per the teachings of The Church established by St Peter, it says that the Godliness and Humanity in Yeshua were conjoined and in a real, perfect, indivisible and inseparable manner as ONE. Hence Yeshua was 100% Human and at the same time 100% God.
| Verse from The Old Testament / Tanakh |
|---|
| Leviticus 6: 25 - 27 “Speak to Aaron and to his sons, saying, ‘This is the law of the sin offering: In the place where the burnt offering is killed, the sin offering shall be killed before the LORD. It is most holy. ‘The priest who offers it for sin shall eat it. In a holy place it shall be eaten, in the court of the tabernacle of meeting. Everyone who touches its flesh must be holy. And when its blood is sprinkled on any garment, you shall wash that on which it was sprinkled, in a holy place. |
| Jeremiah 7: 21 Thus says the LORD of hosts, the God of Israel: “Add your burnt offerings to your sacrifices and eat meat." |
| Verse |
|---|
| John 6: 53 - 58 Then Jesus said to them, “Most assuredly, I say to you, unless you eat the flesh of the Son of Man and drink His blood, you have no life in you. Whoever eats My flesh and drinks My blood has eternal life, and I will raise him up at the last day. For My flesh is food indeed, and My blood is drink indeed. “He who eats My flesh and drinks My blood abides in Me, and I in him. As the living Father sent Me, and I live because of the Father, so he who feeds on Me will live because of Me. This is the bread which came down from heaven—not as your fathers ate the manna, and are dead. He who eats this bread will live forever. |
| Mathew 26: 26 -28 And as they were eating, Jesus took bread, blessed[fn] and broke it, and gave it to the disciples and said, “Take, eat; this is My body.” Then He took the cup, and gave thanks, and gave it to them, saying, “Drink from it, all of you. “For this is My blood of the new covenant, which is shed for many for the remission of sins. |
| Verse from the Holy Bible |
|---|
| Luke 21: 19 And He took bread, gave thanks and broke it, and gave it to them, saying, “This is My body which is given for you; do this in remembrance of Me.” |
| 1 Corinthians 11: 26 For as often as you eat this bread and drink this cup, you proclaim the Lord’s death till He comes. |
Blood of Yeshuwa was ALIVE in lab analysis

Flesh and Blood of Yeshuwa offered as Bread and Wine at Church

High Priest will enter the Altar for the people of Israel

Yeshua as the ETERNAL High Priest as He is still Living and entered the Heavenly Holy of Holies

High Priest has to put the Blood on the mercy seat

Yeshua as High Priest, put His blood on the mercy seat

There should be a sacrifice of Blood as offering

Yeshua offered His own blood as offering
This Bread is LIVING as per RON WYATT lab test,
So This 'Flesh' still belongs to Yeshuwa, the lamb, crucified in 29 A.D. and His Blood is still on the mercy seat.
'I am the living bread that came down from heaven. Whoever eats of this bread will live forever; and the bread that I will give for the life of the world is my flesh.' - John 6: 51

The flesh of sacrifical animal should be burnt by the Priest.

The ordained Priests preparing the Holy bread by burning.

The Priest offers sacrifice with incenses and smoke

The High priest offers prayers with incense and smoke.

The Burnt flesh will be consumed by Priest and the people of Israel in the Temple Of Jerusalem.

The living flesh of Yeshua as Bread, is consumed by the Priest and Christians in the Holy Church. The sour in this Bread dates back to The Last Supper

The living bread is still available to the multitude through
The Church Of Antioch.
Many tried to eliminate the Holy Bread of the Church of Antioch without knowing its importance. The 'sour' in Holy Bread is the same that was used by Yeshua during Last supper. The same bread is continued through the Church of Antioch that was established by St. Peter, the Rock.
In order to receive the Holy Bread, it is mandatory that the person receives the baptism from the Holy Church. Hence the name will be entered into the Holy Book at Heaven.
This is equivalent to circumcision received by the Israelites during Old Testament.